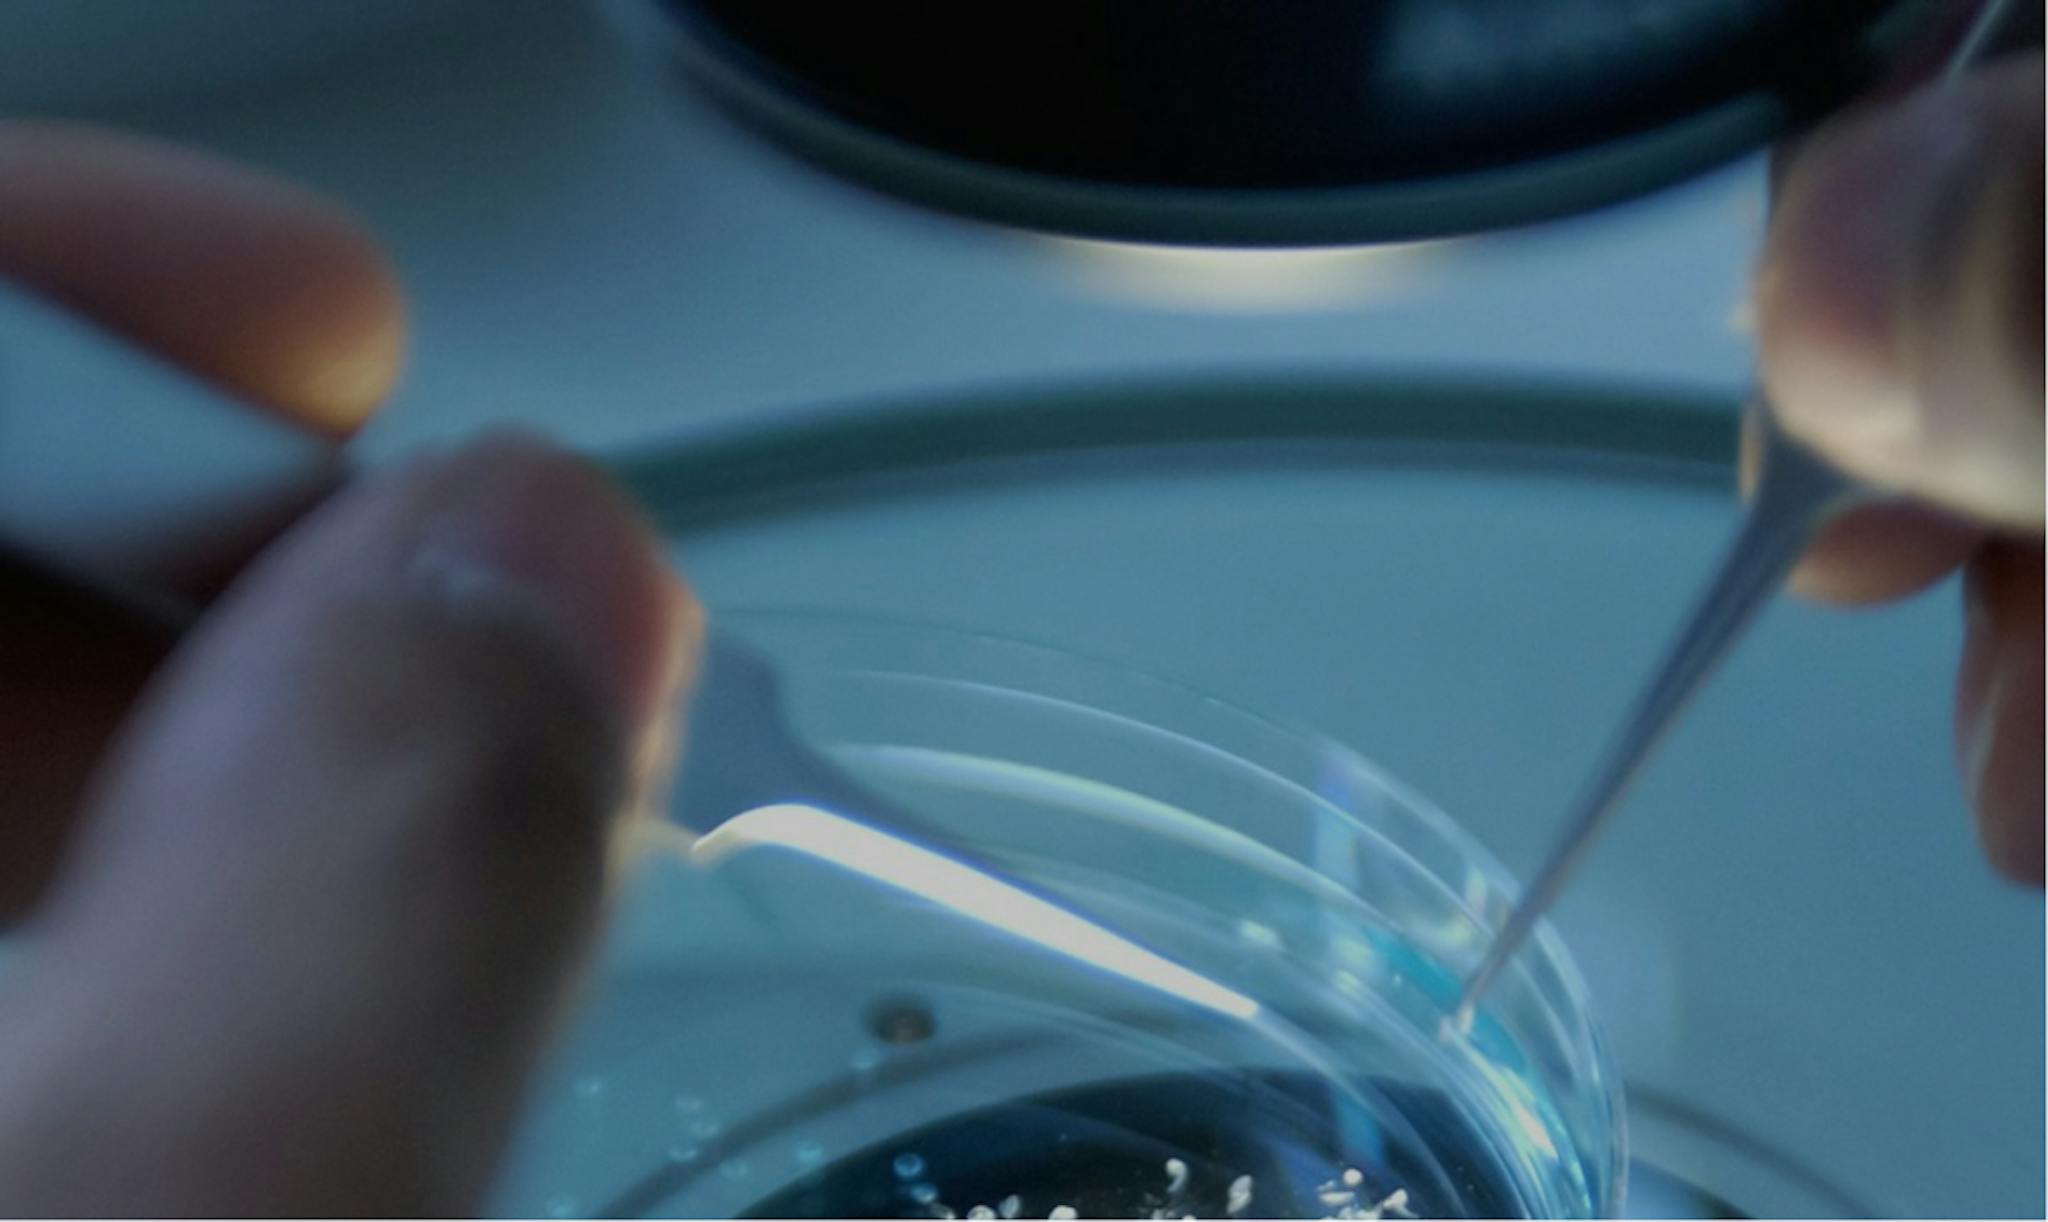

WhitepapersInvesting in the science that defines tomorrow’s medicine
Luma Group funds early and mid-stage biotechnology companies. Our approach integrates AI-driven analysis, scientific rigor, and an advisor network spanning research, clinical practice, and industry leadership.
Scientific rigor enhanced by AI
We pair deep scientific discipline with advanced AI to evaluate opportunities with clarity and precision.
Accelerated insight with LABI
Our AI system speeds up how we analyze data, validate breakthroughs, and uncover real potential.
Hands-on industry leadership
We work closely with founders through research, development, and scale to turn science into lasting impact.

Breakthrough science. Disciplined execution.
We back early and mid-stage biotech teams advancing therapeutics, platform technologies, and biological computation—supporting solutions that can meaningfully scale human health.
Research, analysis, and updates from our network
Articles, whitepapers, and expert commentary.